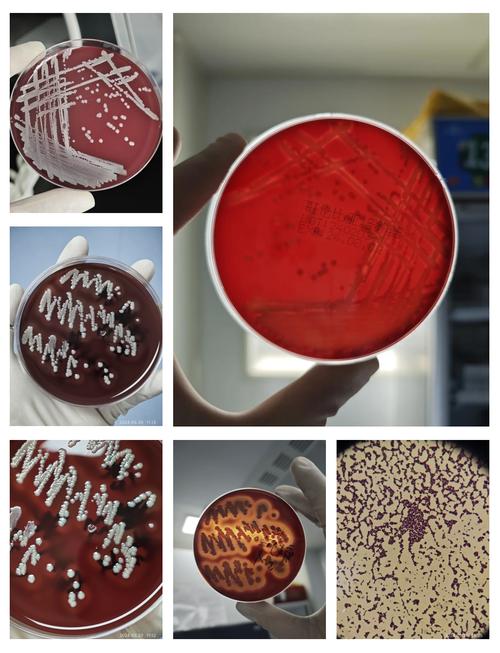
新生儿人葡萄球菌亚种-第2张图片-郑州医学网

新生儿人葡萄球菌亚种 指的是 “人葡萄球菌” 这个细菌在 新生儿 这个特定人群中引起的感染或定植。

(图片来源网络,侵删)
下面我将从几个方面为您详细拆解:
什么是“人葡萄球菌”?
- 分类:人葡萄球菌(Staphylococcus hominis)是葡萄球菌属(Staphylococcus)的一种,它属于 凝固酶阴性葡萄球菌。
- 特点:
- 常驻菌:它是人体皮肤和黏膜的正常菌群之一,通常定植于腋窝、腹股沟、会阴等温暖潮湿的部位。
- 低毒力:对于健康的、免疫力正常的人来说,它通常是无害的,不会引起疾病。
- 机会致病菌:当人体的免疫力下降、皮肤屏障受损或有其他侵入性操作(如插管)时,它就可能“趁虚而入”,导致感染。
为什么特别关注“新生儿”?
新生儿的生理特点使他们特别容易受到人葡萄球菌等机会致病菌的威胁:
- 免疫系统不成熟:新生儿,尤其是早产儿,自身的免疫系统尚未发育完全,抵抗力非常弱。
- 皮肤屏障功能不完善:新生儿的皮肤非常娇嫩,角质层薄,容易破损,为细菌入侵提供了“门户”。
- 医疗操作频繁:新生儿,特别是重症监护的新生儿,需要接受各种医疗操作,如静脉置管(PICC/CVC)、气管插管、吸痰等,这些操作会破坏皮肤黏膜的完整性,并将皮肤上的细菌带入体内。
- 住院环境:新生儿病房(NICU)是细菌容易聚集的地方,医护人员和家属都可能成为细菌传播的媒介。
新生儿人葡萄球菌亚种可能引起哪些问题?
当人葡萄球菌在新生儿身上引起感染时,可能表现为以下几种情况:
-
定植 vs. 感染:
(图片来源网络,侵删)
(图片来源网络,侵删)- 定植:只在宝宝的皮肤、鼻腔、脐部等部位发现细菌,但宝宝没有任何症状,也没有炎症反应,这是非常常见的,不需要特殊治疗。
- 感染:细菌侵入身体组织或血液,引发疾病,这需要积极治疗。
-
常见感染类型:
- 皮肤软组织感染:如脓疱疮、小脓肿、脐炎(肚脐发炎)等,表现为局部红、肿、热、痛,或有脓液。
- 导管相关血流感染:这是最严重和最需要警惕的类型,如果宝宝体内有静脉或动脉导管,细菌可能沿着导管进入血液,引起败血症,表现为发烧、体温不升、精神萎靡、吃奶差、呼吸急促等。
- 眼部感染:如结膜炎、眼炎。
- 其他:在极少数情况下,也可能引起肺炎、脑膜炎等严重感染。
医生如何诊断和治疗?
-
诊断:
- 临床表现:医生会根据宝宝的症状和体征进行初步判断。
- 实验室检查:
- 培养:从感染部位(如脓液、脐部分泌物)或血液中取样进行细菌培养,这是确诊的金标准,培养可以明确是哪种细菌,并对其进行药敏试验(即测试哪种抗生素对它最有效)。
- 血常规:查看白细胞、C反应蛋白等炎症指标是否升高。
-
治疗:
- 抗生素:一旦确诊为感染,医生会根据药敏试验结果和临床经验选择敏感的抗生素,由于人葡萄球菌可能对某些常用抗生素产生耐药性,所以药敏试验至关重要。
- 局部处理:对于皮肤感染或脐炎,除了使用抗生素,还需要进行清洁、消毒,保持局部干燥。
- 移除导管:如果是导管相关感染,通常需要拔除或更换导管,并从新导管尖端和外周血同时培养,以确认感染源。
家长和医护人员如何预防?
预防是关键,尤其是在新生儿病房:

(图片来源网络,侵删)
- 严格执行手卫生:这是预防交叉感染最重要的一步,医护人员和家长在接触宝宝前、后都必须用肥皂和流水或速干手消毒剂彻底洗手。
- 做好皮肤护理:保持宝宝皮肤清洁干燥,特别是皮肤褶皱处和脐部,及时更换尿布,防止尿布疹。
- 避免不必要的接触:尽量减少人员探视,避免外人随意触摸宝宝。
- 无菌操作:所有医疗操作都必须严格遵守无菌原则。
- 环境消毒:定期对病房进行清洁和消毒。
“新生儿人葡萄球菌亚种” 并不是一个独立的细菌变种,而是指 “人葡萄球菌” 这种细菌在 新生儿 这个特殊群体中的致病状态,它通常是机会性致病菌,对健康人无害,但对免疫力低下、皮肤屏障受损的新生儿来说,可能引起从局部皮肤感染到致命的败血症等多种疾病。
在新生儿护理中,保持严格的卫生习惯、密切观察宝宝状态,并在出现异常时及时就医,是预防和处理此类问题的关键。
版权声明:除非特别标注,否则均为本站原创文章,转载时请以链接形式注明文章出处。






